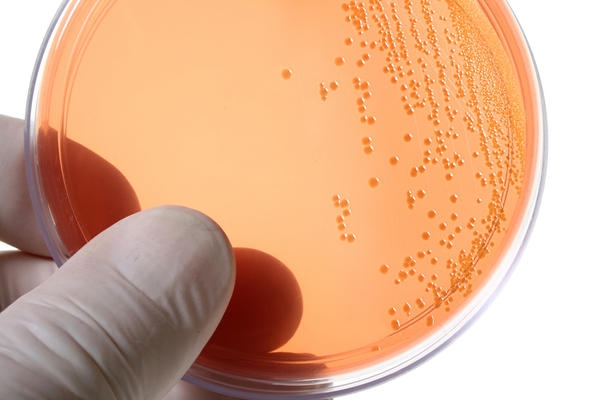
A apărut un nou test pentru depistarea rapidă a Chlamydiei. Află de aici cât costă

Cea mai răspândită boală cu transmitere sexuală la nivel global este Chlamydia trachomatis. Potrivit unui studiu recent, 2,5 la sută - 10 la sută dintre femeile fertile cu vârste cuprinse între 14 şi 24 de ani sunt deja infectate. Infecţia poate afecta ambii parteneri, ducând la complicaţii oculare sau reumatismale.
Mai ales în cazul femeilor gravide, boala poate duce la pierderea sarcinii. Testul disponibil acum în farmacii poartă numele de cyclotest de depistare rapidă a Chlamydiei, putând fi cumpărat la preţul de 100 de lei. Testul este foarte important de făcut mai ales în cazul unei sarcini planificate, întrucât se cunoaşte că aproximativ 50 la sută dintre mamele infectate transmit infecţia nou-născutului. Complicaţiile apărute frecvent la nou-născuţi includ conjunctivita şi "aprinderea" la plămâni.